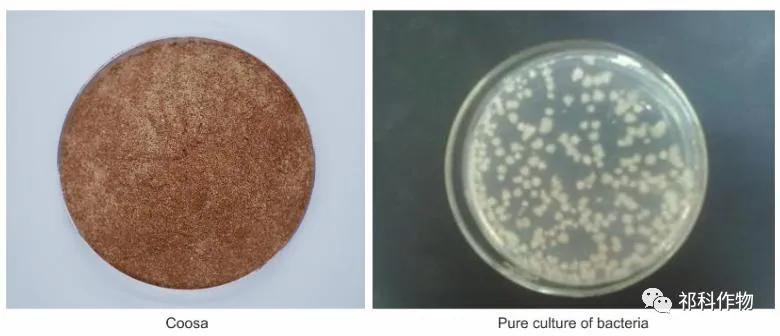

Upgrade Nutrient: Scientific nutrient ratio, better suited for crops needs.
| Upgrade Nutrient Composition | ||
|---|---|---|
| Amino Acid | ≥ 10.0% | |
| N,K | ≥ 11.0% | |
| Total Trace Element | ≥ 2.0% | |
Better Price: Price as fertilizer, Efficacy as fertilizer + acaricide!
COOSA® contains total nutrition of N, K ≥11%, Organic Amino Acid ≥10%, and special functional bacteria. It is a biological, organic and inorganic compound fertilizer with various humic acids, amino acids and beneficial trace elements such as Mg, B, Zn, Fe, Mo, Mn.
It can regulate and improve crop sub-health, reduce crop yellowing, premature aging, etc., and increase chlorophyll, thereby effectively increasing yields. It's fully water-soluble and can be quickly absorbed by crops. It's an excellent foliar and drip irrigation fertilizer.

COOSA® contains special functional biological bacteria—Bacillus amyloliquefaciens and Paenibacillus mucilaginosus. These bacteria secrete metabolites like extracellular epidermal active protein and wax-resolving acids that act on mites rapidly, knocking them down quickly after application.



Targets: Red spider mite, Rust spider mite, Whitefly, Aphid.
Crops: Citrus, Strawberry, Watermelon, Tomato, Eggplant, Corn, Wheat, Rice, Coffee, and more.
| Application Type | Dilution Rate | Expected Effect |
|---|---|---|
| Excellent Foliar Fertilizer | 500~800 times | Glossy, bright and green leaves within 3 days. |
| Fast Knock Down Mites | 170~300 times | Effectively get rid of mites in 10-15 minutes. |
1. Use electric sprayers with fine aerosol; spray evenly on both sides of leaves.
2. Do not mix with copper fungicides or strongly acidic/alkaline chemicals.
3. Avoid adding other fertilizers (like MKP) to prevent high concentration stress.
4. Apply on sunny days when leaves are dry.
5. For high egg populations, mix with ovicidal acaricides.


